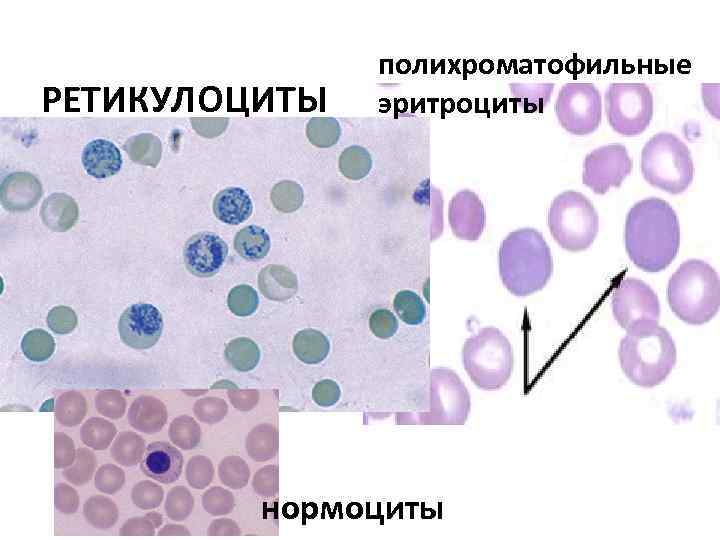
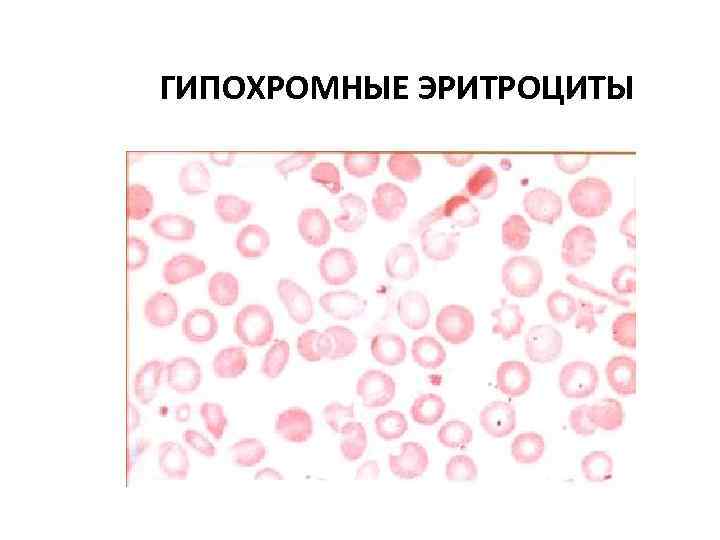
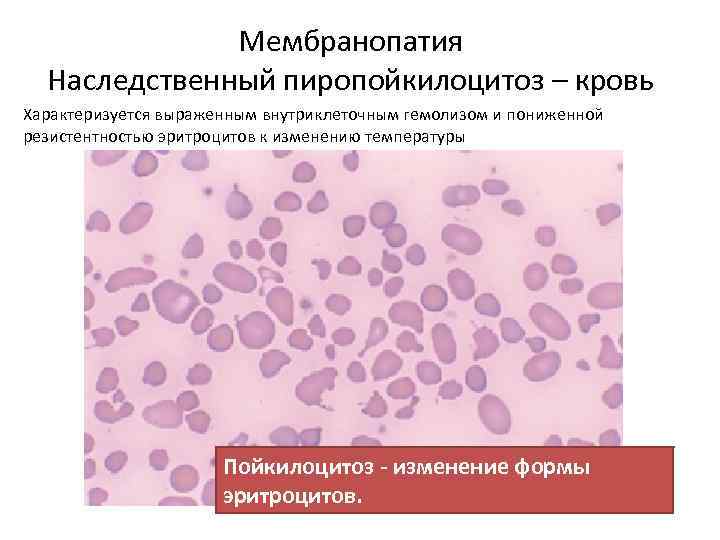
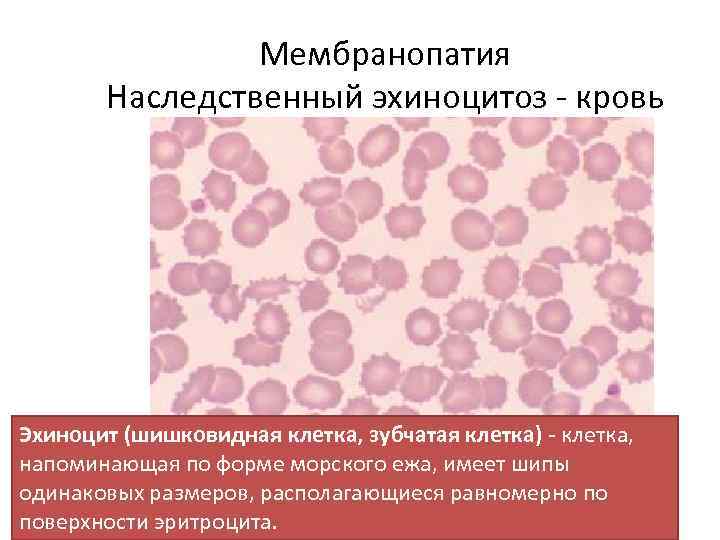
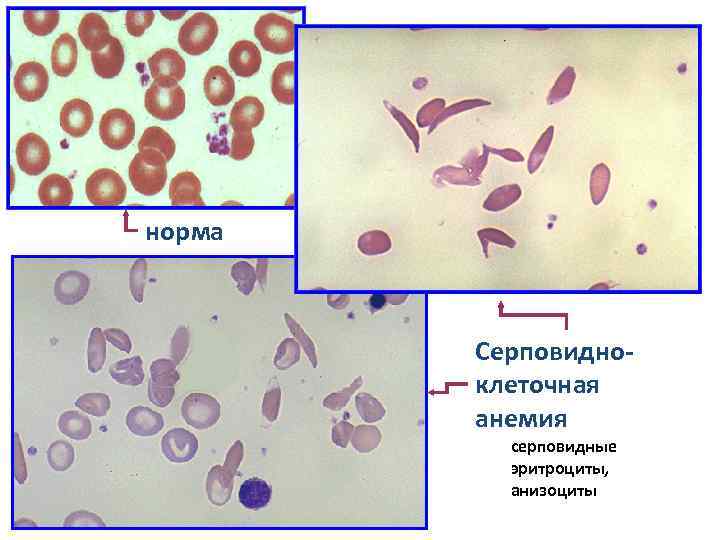
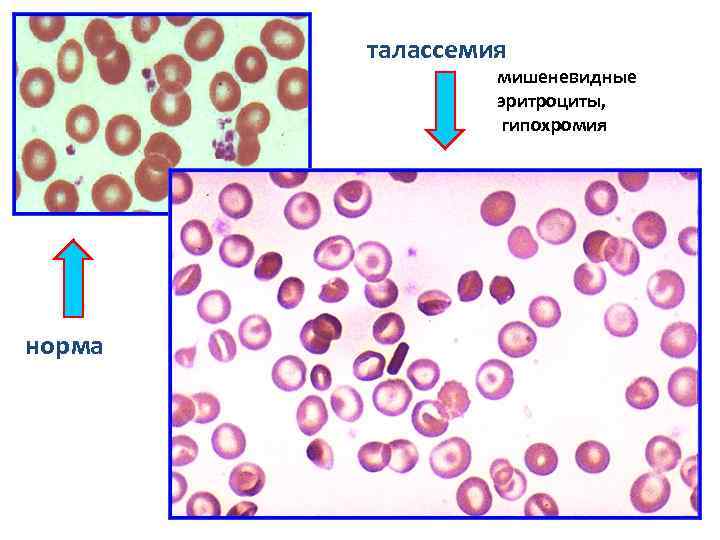

Лекция 4.pptx
- Количество слайдов: 58
 ЛЕКЦИЯ 4 АНЕМИИ. Классификация, патогенез, диагностика Постгеморрагические и гемолитические анемии
ЛЕКЦИЯ 4 АНЕМИИ. Классификация, патогенез, диагностика Постгеморрагические и гемолитические анемии
 АНЕМИИ • Анемии (малокровие) – группа заболеваний, которые характеризуются снижением количества Hb, или Hb и эритроцитов в единице объема крови. • Нb < 120 г/л у женщин и Нb < 140 г/л у мужчин. • От анемии отличают гидремию – разжижение крови за счет притока тканевой жидкости при беременности и сердечной недостаточности. При гидремии объем плазмы увеличивается, уровень гемоглобина и эритроцитов снижается, но общего уменьшения массы гемоглобина и эритроцитов не отмечается.
АНЕМИИ • Анемии (малокровие) – группа заболеваний, которые характеризуются снижением количества Hb, или Hb и эритроцитов в единице объема крови. • Нb < 120 г/л у женщин и Нb < 140 г/л у мужчин. • От анемии отличают гидремию – разжижение крови за счет притока тканевой жидкости при беременности и сердечной недостаточности. При гидремии объем плазмы увеличивается, уровень гемоглобина и эритроцитов снижается, но общего уменьшения массы гемоглобина и эритроцитов не отмечается.
 По патогенезу анемии : • 1) постгеморрагические – в результате кровопотери; • 2) гемолитические – в результате усиленного разрушения эритроцитов; • 3) анемии в результате нарушения эритропоэза • 3. 1) железодефицитные • 3. 2) анемии связанные с нарушением синтеза или утилизации порфиринов (сидеробластные) • 3. 3) анемии, связанные с нарушением синтеза ДНК, РНК (мегалобластные) • 3. 4) анемии связанные с угнетением пролиферации клеток костного мозга (гипопластичесие, апластические) • 3. 5) анемии вызванные вытеснением кроветворной ткани костного мозга опухолевой тканью (метапластическая)
По патогенезу анемии : • 1) постгеморрагические – в результате кровопотери; • 2) гемолитические – в результате усиленного разрушения эритроцитов; • 3) анемии в результате нарушения эритропоэза • 3. 1) железодефицитные • 3. 2) анемии связанные с нарушением синтеза или утилизации порфиринов (сидеробластные) • 3. 3) анемии, связанные с нарушением синтеза ДНК, РНК (мегалобластные) • 3. 4) анемии связанные с угнетением пролиферации клеток костного мозга (гипопластичесие, апластические) • 3. 5) анемии вызванные вытеснением кроветворной ткани костного мозга опухолевой тканью (метапластическая)
 Морфологическая классификация анемий: По велечине цветового показателя • А. Нормохромная анемия (норма 0, 9 1, 1) • Б. Гипохромная анемия (цвет. показат. менее 0, 85) • В. Гиперхромная анемия (цвет. показатель более 1, 15) По величине среднего диаметра эритроцитов: • а. Нормоцитарные (диаметр 7, 2 7, 5) • б. Микроцитарные (6, 5) • в. макроцитарные (8, 0) • г. мегалоцитарные ( равен или более 12 мкм) По уровню ретикулоцитов в ПК (уровень ретикулоцитов является показателем регенераторной функции костного мозга в отношении эритропоэза): • а. Регенераторные (0, 5 5%) • б. Гипперрегенаторные (более 5%) • в. гипо и арегенераторные (количество ретикулоцитов снижено или отсутствует, несмотря на тяжелое течение анемии). По типу кроветворения: • а. Мегалобластическое. (ранняя гемоглобинизация клетки при сохранении нежной структуры ядра. промегалобласт – мегалоцит) • б. Нормобластическое (эритробласт – пронормобласт – эритроцит).
Морфологическая классификация анемий: По велечине цветового показателя • А. Нормохромная анемия (норма 0, 9 1, 1) • Б. Гипохромная анемия (цвет. показат. менее 0, 85) • В. Гиперхромная анемия (цвет. показатель более 1, 15) По величине среднего диаметра эритроцитов: • а. Нормоцитарные (диаметр 7, 2 7, 5) • б. Микроцитарные (6, 5) • в. макроцитарные (8, 0) • г. мегалоцитарные ( равен или более 12 мкм) По уровню ретикулоцитов в ПК (уровень ретикулоцитов является показателем регенераторной функции костного мозга в отношении эритропоэза): • а. Регенераторные (0, 5 5%) • б. Гипперрегенаторные (более 5%) • в. гипо и арегенераторные (количество ретикулоцитов снижено или отсутствует, несмотря на тяжелое течение анемии). По типу кроветворения: • а. Мегалобластическое. (ранняя гемоглобинизация клетки при сохранении нежной структуры ядра. промегалобласт – мегалоцит) • б. Нормобластическое (эритробласт – пронормобласт – эритроцит).
 Клинические и гематологические проявления анемий • Симптомы общие для всех анемий вызванные резвившейся гипоксией (О 2 дефицитом): бледность кожи и слизистых, слабость, головокружение, мелькание «мушек» , шум в ушах, тахикардия, часто субфебрильная Т, одышка. • Симптомы характерные для определенных групп анемий соответственно патогенезу. Например, при гемолитических анемиях – гемолитическая желтуха. При мегалобластных анемиях – нарушения со стороны ЖКТ, развитие радикулита, полиневрита. • Изменения со стороны крови и костно мозгового кроветворения.
Клинические и гематологические проявления анемий • Симптомы общие для всех анемий вызванные резвившейся гипоксией (О 2 дефицитом): бледность кожи и слизистых, слабость, головокружение, мелькание «мушек» , шум в ушах, тахикардия, часто субфебрильная Т, одышка. • Симптомы характерные для определенных групп анемий соответственно патогенезу. Например, при гемолитических анемиях – гемолитическая желтуха. При мегалобластных анемиях – нарушения со стороны ЖКТ, развитие радикулита, полиневрита. • Изменения со стороны крови и костно мозгового кроветворения.
 Основные лабораторные данные для диагностики анемий. Гематологические: • уровень гемоглобина, эритроцитов, количество ретикулоцитов • цветовой показатель, индексы эритроцитов (ср. d, ср. концентрация Hb в эритроцитах. , V эритроцитов и т. д. ). • Гематокрит, соотношения между V плазмы и количества эритроцитов • СОЭ (чаще СОЭ ускоренное, соответственно уменьшению числа эритроцитов в крови, исключение – гемолитическая анемия – наследственный микросфероцитоз и серповидноклеточная анемия, при которой особенная форма эритроцитов мешает их осаждению).
Основные лабораторные данные для диагностики анемий. Гематологические: • уровень гемоглобина, эритроцитов, количество ретикулоцитов • цветовой показатель, индексы эритроцитов (ср. d, ср. концентрация Hb в эритроцитах. , V эритроцитов и т. д. ). • Гематокрит, соотношения между V плазмы и количества эритроцитов • СОЭ (чаще СОЭ ускоренное, соответственно уменьшению числа эритроцитов в крови, исключение – гемолитическая анемия – наследственный микросфероцитоз и серповидноклеточная анемия, при которой особенная форма эритроцитов мешает их осаждению).
 Постгеморрагическая анемия • • Постгеморрагическая анемия подразделяется на острую и хроническую. Острая постгеморрагическая анемия Развивается после значительной кровопотери в результате либо внешних травм с повреждением сосудов, либо кровотечением из внутренних органов. Первые дни после кровопотери она нормохромная, то есть содержание гемоглобина в эритроцитах не уменьшено. Цветной показатель равняется 0, 85 1, 1. Качественные изменения эритроцитов отсутствуют. Быстро снижается общий V крови и прежде всего V плазмы. Снижается количество эритроцитов, развивается гипоксия.
Постгеморрагическая анемия • • Постгеморрагическая анемия подразделяется на острую и хроническую. Острая постгеморрагическая анемия Развивается после значительной кровопотери в результате либо внешних травм с повреждением сосудов, либо кровотечением из внутренних органов. Первые дни после кровопотери она нормохромная, то есть содержание гемоглобина в эритроцитах не уменьшено. Цветной показатель равняется 0, 85 1, 1. Качественные изменения эритроцитов отсутствуют. Быстро снижается общий V крови и прежде всего V плазмы. Снижается количество эритроцитов, развивается гипоксия.
 Острая постгеморрагическая анемия • Внезапное уменьшение количества циркулирующих эритроцитов вызывает гемическую гипоксию, на которую почки реагируют усиленным синтезом эритропоэтина. • Этот пептид считается гормоном эритропоэза, он стимулирует образование и дозревание эритробластов в костном мозге. • Пролиферация эритропоэтичного ростка становится заметной на 4 5 й день после кровопотери. • В крови растет количество ретикулоцитов и полихроматофильных эритроцитов, появляються единичные нормоциты. Эти изменения свидетельствуют о высокой регенераторной способности костного мозга.
Острая постгеморрагическая анемия • Внезапное уменьшение количества циркулирующих эритроцитов вызывает гемическую гипоксию, на которую почки реагируют усиленным синтезом эритропоэтина. • Этот пептид считается гормоном эритропоэза, он стимулирует образование и дозревание эритробластов в костном мозге. • Пролиферация эритропоэтичного ростка становится заметной на 4 5 й день после кровопотери. • В крови растет количество ретикулоцитов и полихроматофильных эритроцитов, появляються единичные нормоциты. Эти изменения свидетельствуют о высокой регенераторной способности костного мозга.
 Клиника. Острая постгеморрагическая анемия • Клиника. Тяжесть клинической картины зависит от количества потерянной крови. Появляется резкая бледность, слабость, головокружение, холодный пот, давление падает, цианоз, рвота, коллапс. • Уже во время кровотечения включаются компенсаторные механизмы организма. Надпочечники выбрасывают катехоламин. Что приводит к быстрому спазму сосудов и падению объема циркулирующей крови. В первые 1 2 дня после кровопотери количества Hb и эритроцитов в норме или чуть ниже нормы. Через 2 3 дня в кровоток поступает много тканевой жидкости, объем циркулирующей крови восстанавливается до первоначального. Hb и эритроциты равномерно снижаются. Анемия нормохромная. Через 4 5 дней после кровопотери в крови наблюдается ретикулоцитоз, полихроматофилия, еденичные нормобласты. Это проявление компесаторной реакции к/м на кровопотерю
Клиника. Острая постгеморрагическая анемия • Клиника. Тяжесть клинической картины зависит от количества потерянной крови. Появляется резкая бледность, слабость, головокружение, холодный пот, давление падает, цианоз, рвота, коллапс. • Уже во время кровотечения включаются компенсаторные механизмы организма. Надпочечники выбрасывают катехоламин. Что приводит к быстрому спазму сосудов и падению объема циркулирующей крови. В первые 1 2 дня после кровопотери количества Hb и эритроцитов в норме или чуть ниже нормы. Через 2 3 дня в кровоток поступает много тканевой жидкости, объем циркулирующей крови восстанавливается до первоначального. Hb и эритроциты равномерно снижаются. Анемия нормохромная. Через 4 5 дней после кровопотери в крови наблюдается ретикулоцитоз, полихроматофилия, еденичные нормобласты. Это проявление компесаторной реакции к/м на кровопотерю
РЕТИКУЛОЦИТЫ полихроматофильные эритроциты нормоциты
РЕТИКУЛОЦИТЫ полихроматофильные эритроциты нормоциты
 Острая постгеморрагическая анемия В условиях большой кровопотери • В условиях быстрого дозревания эритроциты не успевают накопить достаточного количества гемоглобина. Цветной показатель постепенно снижается до 0, 8 и ниже, нормохромная анемия переходит в гипохромную. • Имеет значение и то, что после кровопотери истощаются резервы железа, необходимого для синтеза гемоглобина. На этом этапе в крови появляються эритроциты с низким содержанием гемоглобина, которые под микроскопом имеют вид бубликов с просветлением посередине (гипохромные эритроциты).
Острая постгеморрагическая анемия В условиях большой кровопотери • В условиях быстрого дозревания эритроциты не успевают накопить достаточного количества гемоглобина. Цветной показатель постепенно снижается до 0, 8 и ниже, нормохромная анемия переходит в гипохромную. • Имеет значение и то, что после кровопотери истощаются резервы железа, необходимого для синтеза гемоглобина. На этом этапе в крови появляються эритроциты с низким содержанием гемоглобина, которые под микроскопом имеют вид бубликов с просветлением посередине (гипохромные эритроциты).
ГИПОХРОМНЫЕ ЭРИТРОЦИТЫ
ГИПОХРОМНЫЕ ЭРИТРОЦИТЫ
 Хроническая постгеморрагическая анемия • следствие длительных повторных кровопотерь у больных с язвенной болезнью желудка и двенадцатиперстной кишки, раком желудка, геморроем, гемофилией, у женщин с маточными кровотечениями. • В костном мозге наблюдаются явления выраженной регенерации, появляются очаги экстрамедулярного кроветворения. В результате истощения запасов железа анемия постепенно приобретает гипохромный характер. • В кровь выбрасываются гипохромные эритроциты и микроциты. Со временем эритропоэтическая функция костного мозга подавляется, и анемия становится гипорегенераторной. • В связи с гипоксией развивается жировая дистрофия миокарда, печени, почек, возникают дистрофические изменения в клетках головного мозга. Появляються множественные точечные кровоизлияния в коже, слизистых и серозных оболочках, внутренних органов.
Хроническая постгеморрагическая анемия • следствие длительных повторных кровопотерь у больных с язвенной болезнью желудка и двенадцатиперстной кишки, раком желудка, геморроем, гемофилией, у женщин с маточными кровотечениями. • В костном мозге наблюдаются явления выраженной регенерации, появляются очаги экстрамедулярного кроветворения. В результате истощения запасов железа анемия постепенно приобретает гипохромный характер. • В кровь выбрасываются гипохромные эритроциты и микроциты. Со временем эритропоэтическая функция костного мозга подавляется, и анемия становится гипорегенераторной. • В связи с гипоксией развивается жировая дистрофия миокарда, печени, почек, возникают дистрофические изменения в клетках головного мозга. Появляються множественные точечные кровоизлияния в коже, слизистых и серозных оболочках, внутренних органов.
 Гемолитические анемии • Группа анемий, основным признаком которых является повышенный распад эритроцитов и укорочение продолжительности их жизни. • наследственные и приобретенные формы гемолитических анемий. • Наследственные гемолитические анемии являются следствием различных генетических дефектов в эритроцитах, которые становятся функционально неполноценными и нестойкими. • Приобретенные, гемолитические анемии связаны с воздействием различных факторов, способствующих разрушению эритроцитов (образование антител, гемолитические яды, медикаменты, механические воздействия и пр. ).
Гемолитические анемии • Группа анемий, основным признаком которых является повышенный распад эритроцитов и укорочение продолжительности их жизни. • наследственные и приобретенные формы гемолитических анемий. • Наследственные гемолитические анемии являются следствием различных генетических дефектов в эритроцитах, которые становятся функционально неполноценными и нестойкими. • Приобретенные, гемолитические анемии связаны с воздействием различных факторов, способствующих разрушению эритроцитов (образование антител, гемолитические яды, медикаменты, механические воздействия и пр. ).
 Разрушение эритроцитов в норме • Продолжительность жизни эритроцитов 100 120 дней. • 90% эритроцитов разрушается в МФ селезенки, где из гемоглобина образуется пигмент билирубин (свободный =неконьюгированный), транспортируется в печеночную клетку, где соединяется с глюкуроновой кислотой. Образовавшийся билирубин глюкуронид (конъюгированный=прямой) проникает из печеночных клеток в желчные ходы и выделяется вместе с желчью в кишечник, где превращается в стеркобилиноген. Небольшая часть стеркобилиногена попадает путем всасывания через слизистую оболочку толстого кишечника в систему нижней полой вены, доставляется с кровью в почки и выделяется с мочой в виде стеркобилина (уробилина). • 10% эритроцитов разрушаются в капиллярах с выделением свободного Гб. Свободный Гб связывается с белком плазмы гаптоглобином. Связанный с гаптоглобином Гб не проходит через почечный фильтр.
Разрушение эритроцитов в норме • Продолжительность жизни эритроцитов 100 120 дней. • 90% эритроцитов разрушается в МФ селезенки, где из гемоглобина образуется пигмент билирубин (свободный =неконьюгированный), транспортируется в печеночную клетку, где соединяется с глюкуроновой кислотой. Образовавшийся билирубин глюкуронид (конъюгированный=прямой) проникает из печеночных клеток в желчные ходы и выделяется вместе с желчью в кишечник, где превращается в стеркобилиноген. Небольшая часть стеркобилиногена попадает путем всасывания через слизистую оболочку толстого кишечника в систему нижней полой вены, доставляется с кровью в почки и выделяется с мочой в виде стеркобилина (уробилина). • 10% эритроцитов разрушаются в капиллярах с выделением свободного Гб. Свободный Гб связывается с белком плазмы гаптоглобином. Связанный с гаптоглобином Гб не проходит через почечный фильтр.

 Патологический гемолиз • При гемолитических анемиях вследствие усиленного разрушения эритроцитов продолжительность их жизни укорачивается до 12 – 14 дней. • Патологический гемолиз может быть внутриклеточным или внутрисосудистым.
Патологический гемолиз • При гемолитических анемиях вследствие усиленного разрушения эритроцитов продолжительность их жизни укорачивается до 12 – 14 дней. • Патологический гемолиз может быть внутриклеточным или внутрисосудистым.
 Патологический гемолиз • Внутриклеточный распад эритроцитов происходит в клетках ретикуло эндотелиальной системы, главным образом в селезенке. • Нормальные эритроциты уплощаются и легко проходят через синусы селезенки через узкие места кровотока. Эритроциты в форме сфероцитов задерживаются в синусах, разрушаются и фагоцитируются МФ. При этом часто наблюдается желтуха и спленомегалия. • Уровень гаптоглобина остается нормальным или слегка понижен, отмечается непрямая гипербилирубинемия.
Патологический гемолиз • Внутриклеточный распад эритроцитов происходит в клетках ретикуло эндотелиальной системы, главным образом в селезенке. • Нормальные эритроциты уплощаются и легко проходят через синусы селезенки через узкие места кровотока. Эритроциты в форме сфероцитов задерживаются в синусах, разрушаются и фагоцитируются МФ. При этом часто наблюдается желтуха и спленомегалия. • Уровень гаптоглобина остается нормальным или слегка понижен, отмечается непрямая гипербилирубинемия.
 Патологический гемолиз • При внутрисосудистом гемолизе разрушение эритроцитов происходит в капиллярах почек (почечный гемолиз). • Свободный Гб поступает в повышенном количестве в плазму и если его содержание выше 1 г/л, то он весь связаться с гаптоглобином не может. • Избыток его проходит через почечный фильтр и выделяется с мочой в неизменном виде, за счет чего она становится темно коричневого или черного цвета (гемоглобинурия). • При прохождении через канальцы почек Гб частично разрушается откладывается в эпителии канальцев, появляется в моче в виде гемосидерина (гемосидеринурия). • Последний может откладываться во внутренних органах (гемосидероз). • Может протекать с лихорадкой, ознобом, тахикардией и болью в спине. Уровень гаптоглобина сыворотки по нижен, так как этот белок связывается со свободным гемоглобином. При тяжелом гемолизе свободный гемоглобин определяется в плазме и моче. Гемоглобинурия может стать причиной почечной недостаточ ности. Начиная с 7 сут от гемолитического криза в моче выявляется гемосидерин.
Патологический гемолиз • При внутрисосудистом гемолизе разрушение эритроцитов происходит в капиллярах почек (почечный гемолиз). • Свободный Гб поступает в повышенном количестве в плазму и если его содержание выше 1 г/л, то он весь связаться с гаптоглобином не может. • Избыток его проходит через почечный фильтр и выделяется с мочой в неизменном виде, за счет чего она становится темно коричневого или черного цвета (гемоглобинурия). • При прохождении через канальцы почек Гб частично разрушается откладывается в эпителии канальцев, появляется в моче в виде гемосидерина (гемосидеринурия). • Последний может откладываться во внутренних органах (гемосидероз). • Может протекать с лихорадкой, ознобом, тахикардией и болью в спине. Уровень гаптоглобина сыворотки по нижен, так как этот белок связывается со свободным гемоглобином. При тяжелом гемолизе свободный гемоглобин определяется в плазме и моче. Гемоглобинурия может стать причиной почечной недостаточ ности. Начиная с 7 сут от гемолитического криза в моче выявляется гемосидерин.
 Лабораторная диагностика гемолитических анемий • • • бледность кожных покровов с желтушным оттенком повышение уровня непрямого билирубина в сыворотке снижение сывороточного гаптоглобина при тяжелом гемолизе снижение гемоглобина и гемоглобинурия. Отмечается изменение формы эритроцитов: микросфероциты, мишеневидные и т. д. Осмотическая резистентность резко снижается. В зависимости от степени гемолиза отмечается рост числа ретикулоцитов. Число тромбоцитов в норме. Число лейкоцитов в период кризисов растет, с нейтрофильным сдвигом влево. Все гемолитические анемии нормо или гиперхромные, за исключением талассемии, которая всегда гипохромная.
Лабораторная диагностика гемолитических анемий • • • бледность кожных покровов с желтушным оттенком повышение уровня непрямого билирубина в сыворотке снижение сывороточного гаптоглобина при тяжелом гемолизе снижение гемоглобина и гемоглобинурия. Отмечается изменение формы эритроцитов: микросфероциты, мишеневидные и т. д. Осмотическая резистентность резко снижается. В зависимости от степени гемолиза отмечается рост числа ретикулоцитов. Число тромбоцитов в норме. Число лейкоцитов в период кризисов растет, с нейтрофильным сдвигом влево. Все гемолитические анемии нормо или гиперхромные, за исключением талассемии, которая всегда гипохромная.
 Наследственные гемолитические анемии • а) мембранопатии – связанные с нарушением структуры и обновления белковых и липидных компонентов мембран эритроцитов; • б) ферментопатии – связанные с дефицитом эритроцитарных ферментов, которые обеспечивают пентозо фосфатный цикл, гликолиз, синтез АТФ и порфиринов, обмен нуклеотидов и глютатиона; • в) гемоглобинопатии – связанные с нарушением структуры или синтеза цепей гемоглобина.
Наследственные гемолитические анемии • а) мембранопатии – связанные с нарушением структуры и обновления белковых и липидных компонентов мембран эритроцитов; • б) ферментопатии – связанные с дефицитом эритроцитарных ферментов, которые обеспечивают пентозо фосфатный цикл, гликолиз, синтез АТФ и порфиринов, обмен нуклеотидов и глютатиона; • в) гемоглобинопатии – связанные с нарушением структуры или синтеза цепей гемоглобина.
 Наследственные гемолитические анемии. мембранопатии • Наследственный микросфероцитоз (болезнь Минковского Шоффара ) • наследственный элиптоцитоз • наследственный пиропойкилоцитоз • наследственный стоматоцитоз • наследственный акантоцитоз • наследственный эхиноцитоз
Наследственные гемолитические анемии. мембранопатии • Наследственный микросфероцитоз (болезнь Минковского Шоффара ) • наследственный элиптоцитоз • наследственный пиропойкилоцитоз • наследственный стоматоцитоз • наследственный акантоцитоз • наследственный эхиноцитоз
 Микросфероцитоз (болезнь Минковского Шоффара) • Наследственная мембранопатия с аутосомно доминантным типом наследования. • Мембранный дефект заключается в высокой проницательности эритроцитарных оболочек для ионов натрия. В эритроциты направляется вода, и они приобретают сферическую форму (сфероциты) • Причиной высокой пропускной способности мембран для натрия считается нарушение их белковой и липидной структуры. В частности, обнаружено отсутствие или аномальное строение одного из мембранных белков – спектрина, а также уменьшение содержания липидов. • сферическую форма клеток ведет к замедлению продвижения эритроцитов в синусах селезенки, отщеплению части поверхности эритроцита с образованием микросфероцитов (отсюда название болезни – “микросфероцитоз”) и постепенной их гибели. Разрушенные эритроциты поглощаются макрофагами селезенки. • Постоянный гемолиз эритроцитов в селезенке ведет к гиперплазии клеток ее пульпы и увеличению органа. • В связи с усиленным распадом эритроцитов в сыворотке повышается содержание свободного билирубина.
Микросфероцитоз (болезнь Минковского Шоффара) • Наследственная мембранопатия с аутосомно доминантным типом наследования. • Мембранный дефект заключается в высокой проницательности эритроцитарных оболочек для ионов натрия. В эритроциты направляется вода, и они приобретают сферическую форму (сфероциты) • Причиной высокой пропускной способности мембран для натрия считается нарушение их белковой и липидной структуры. В частности, обнаружено отсутствие или аномальное строение одного из мембранных белков – спектрина, а также уменьшение содержания липидов. • сферическую форма клеток ведет к замедлению продвижения эритроцитов в синусах селезенки, отщеплению части поверхности эритроцита с образованием микросфероцитов (отсюда название болезни – “микросфероцитоз”) и постепенной их гибели. Разрушенные эритроциты поглощаются макрофагами селезенки. • Постоянный гемолиз эритроцитов в селезенке ведет к гиперплазии клеток ее пульпы и увеличению органа. • В связи с усиленным распадом эритроцитов в сыворотке повышается содержание свободного билирубина.
 Наследственный микросфероцитоз (болезнь Минковского Шоффара ) Кровь. Сфероциты эритроциты, утратившие свою двояковогнутую форму. Имеют шаровидную форму, большую толщину, у них отсутствует центральное просветление.
Наследственный микросфероцитоз (болезнь Минковского Шоффара ) Кровь. Сфероциты эритроциты, утратившие свою двояковогнутую форму. Имеют шаровидную форму, большую толщину, у них отсутствует центральное просветление.
 Наследственный микросфероцитоз (болезнь Минковского Шоффара ) • Клиника. Анемический синдром, желтушность кожи и слизистых, спленомегалия, врожденные аномалии костной системы нарушения лицевого скелета в виде башенного черепа, седловидного носа, высокого стояния неба, нарушения расположения зубов, узких глазниц. • Течение заболевания характеризуется гемолитическими кризами, проявляющимися резким усилением симптомов на фоне непрерывно текущего гемолиза. При этом повышается температура тела в связи с массовым распадом эритроцитов, увеличивается интенсивность желтухи, появляются сильные боли в животе, рвота. • Лабораторная диагностика. Анемия нормохромная. В мазке преобладают микросфероциты. Количество ретикулоцитов увеличено. Число лейкоцитов обычно нормально. Содержание непрямого билирубина в крови повышено умеренно. Определяется повышенное содержание уробилина в моче и стеркобилина в кале. • Терапия. Спленэктомия, которая оказывается эффективной в 100 % случаев. Многие больные доживают до старости.
Наследственный микросфероцитоз (болезнь Минковского Шоффара ) • Клиника. Анемический синдром, желтушность кожи и слизистых, спленомегалия, врожденные аномалии костной системы нарушения лицевого скелета в виде башенного черепа, седловидного носа, высокого стояния неба, нарушения расположения зубов, узких глазниц. • Течение заболевания характеризуется гемолитическими кризами, проявляющимися резким усилением симптомов на фоне непрерывно текущего гемолиза. При этом повышается температура тела в связи с массовым распадом эритроцитов, увеличивается интенсивность желтухи, появляются сильные боли в животе, рвота. • Лабораторная диагностика. Анемия нормохромная. В мазке преобладают микросфероциты. Количество ретикулоцитов увеличено. Число лейкоцитов обычно нормально. Содержание непрямого билирубина в крови повышено умеренно. Определяется повышенное содержание уробилина в моче и стеркобилина в кале. • Терапия. Спленэктомия, которая оказывается эффективной в 100 % случаев. Многие больные доживают до старости.
 Мембранопатия Наследственный элиптоцитоз – кровь Эллиптоцит (овалоцит) клетка овальной или удлиненной формы.
Мембранопатия Наследственный элиптоцитоз – кровь Эллиптоцит (овалоцит) клетка овальной или удлиненной формы.
Мембранопатия Наследственный пиропойкилоцитоз – кровь Характеризуется выраженным внутриклеточным гемолизом и пониженной резистентностью эритроцитов к изменению температуры Пойкилоцитоз изменение формы эритроцитов.
Мембранопатия Наследственный пиропойкилоцитоз – кровь Характеризуется выраженным внутриклеточным гемолизом и пониженной резистентностью эритроцитов к изменению температуры Пойкилоцитоз изменение формы эритроцитов.
 Мембранопатия Наследственный стоматоцитоз – кровь Стоматоциты эритроциты, у которых центральное просветление имеет не округлую, а линейную форму, что напоминает ротовое отверстие.
Мембранопатия Наследственный стоматоцитоз – кровь Стоматоциты эритроциты, у которых центральное просветление имеет не округлую, а линейную форму, что напоминает ротовое отверстие.
 Мембранопатия Наследственный акантоцитоз– кровь Акантоцит (листообразная клетка, шпорообразная клетка) эритроцит с выпячиваниями различной величины, расположенными на разных расстояниях друг от друга.
Мембранопатия Наследственный акантоцитоз– кровь Акантоцит (листообразная клетка, шпорообразная клетка) эритроцит с выпячиваниями различной величины, расположенными на разных расстояниях друг от друга.
Мембранопатия Наследственный эхиноцитоз кровь Эхиноцит (шишковидная клетка, зубчатая клетка) клетка, напоминающая по форме морского ежа, имеет шипы одинаковых размеров, располагающиеся равномерно по поверхности эритроцита.
Мембранопатия Наследственный эхиноцитоз кровь Эхиноцит (шишковидная клетка, зубчатая клетка) клетка, напоминающая по форме морского ежа, имеет шипы одинаковых размеров, располагающиеся равномерно по поверхности эритроцита.
 Наследственные гемолитические анемии. Ферментопатии • В основе патогенеза лежит дефицит активности некоторых ферментов эритроцитов, в результате чего эритроциты становятся чувствительными к воздействию различных веществ растительного происхождения, лекарственных средств. • Наиболее распространенной среди этой группы заболеваний является гемолитическая анемия, связанная с дефицитом глюкозо 6 фосфатде гидрогеназы (Г 6 ФДГ). • В СНГ Г 6 ФДГ наиболее распространен среди жителей Армении и Азербайджана. Кроме того, носительство патологического гена описано у таджиков, грузин, русских.
Наследственные гемолитические анемии. Ферментопатии • В основе патогенеза лежит дефицит активности некоторых ферментов эритроцитов, в результате чего эритроциты становятся чувствительными к воздействию различных веществ растительного происхождения, лекарственных средств. • Наиболее распространенной среди этой группы заболеваний является гемолитическая анемия, связанная с дефицитом глюкозо 6 фосфатде гидрогеназы (Г 6 ФДГ). • В СНГ Г 6 ФДГ наиболее распространен среди жителей Армении и Азербайджана. Кроме того, носительство патологического гена описано у таджиков, грузин, русских.
 Наследственные гемолитические анемии. Дефицит глюкозо 6 фосфатдегидрогеназы • Болезнь наследуется доминантно, сцепленная с Х хромосомой, в связи с чем клинические проявления данной патологии наблюдаются преимущественно у мужчин • Постоянная анемия наблюдается редко. • Как правило, болезнь проявляется гемолитическими кризисами после приема некоторых лекарств, которые • способны окислить гемоглобин и выключить его из дыхательной функции. У здоровых лиц этого не происходит благодаря существованию антиоксидантной системы, важным компонентом которой является восстановленный глютатион.
Наследственные гемолитические анемии. Дефицит глюкозо 6 фосфатдегидрогеназы • Болезнь наследуется доминантно, сцепленная с Х хромосомой, в связи с чем клинические проявления данной патологии наблюдаются преимущественно у мужчин • Постоянная анемия наблюдается редко. • Как правило, болезнь проявляется гемолитическими кризисами после приема некоторых лекарств, которые • способны окислить гемоглобин и выключить его из дыхательной функции. У здоровых лиц этого не происходит благодаря существованию антиоксидантной системы, важным компонентом которой является восстановленный глютатион.
 Наследственные гемолитические анемии. Дефицит глюкозо 6 фосфатдегидрогеназы • При дефиците глюкозо 6 фосфатдегидрогеназы, количество восстановленного НАДФ и глютатиона уменьшается. Поэтому медикаменты с окислительными свойствами даже в терапевтических дозах окисляют и разрушают гемоглобин. От его молекулы отрывается гем, а цепи глобина выпадают в осадок (тельца Гейнца). • Эти включения элиминируются в селезенке, но в процессе их удаления теряется часть поверхности эритроцита, который после этого быстро распадается в кровеносном русле. Гемолиз внутрисосудистый.
Наследственные гемолитические анемии. Дефицит глюкозо 6 фосфатдегидрогеназы • При дефиците глюкозо 6 фосфатдегидрогеназы, количество восстановленного НАДФ и глютатиона уменьшается. Поэтому медикаменты с окислительными свойствами даже в терапевтических дозах окисляют и разрушают гемоглобин. От его молекулы отрывается гем, а цепи глобина выпадают в осадок (тельца Гейнца). • Эти включения элиминируются в селезенке, но в процессе их удаления теряется часть поверхности эритроцита, который после этого быстро распадается в кровеносном русле. Гемолиз внутрисосудистый.
 Клиника. Дефицит глюкозо 6 фосфатдегидрогеназы • Клиника. Спровоцировать гемолитический криз могут противо малярийные препараты, сульфаниламиды, анальгетики, некоторые химиопрепараты, витамин К, растительные продукты (бобовые, стручковые). • Гемолиз наступает не сразу, а через 2 – 3 дня после приема препаратов. В тяжелых случаях у больных появляются высокая температура, резкая слабость, боли в животе и спине, обильная рвота. Характерным симптомом является выделение темной мочи, иногда черного цвета, что связано с внутрисосудистым распадом эритроцитов и выделением с мочой гемосидерина. В некоторых случаях вследствие закупорки почечных канальцев продуктами распада гемоглобина и резкого снижения клубочковой фильтрации возможно развитие острой почечной недостаточности.
Клиника. Дефицит глюкозо 6 фосфатдегидрогеназы • Клиника. Спровоцировать гемолитический криз могут противо малярийные препараты, сульфаниламиды, анальгетики, некоторые химиопрепараты, витамин К, растительные продукты (бобовые, стручковые). • Гемолиз наступает не сразу, а через 2 – 3 дня после приема препаратов. В тяжелых случаях у больных появляются высокая температура, резкая слабость, боли в животе и спине, обильная рвота. Характерным симптомом является выделение темной мочи, иногда черного цвета, что связано с внутрисосудистым распадом эритроцитов и выделением с мочой гемосидерина. В некоторых случаях вследствие закупорки почечных канальцев продуктами распада гемоглобина и резкого снижения клубочковой фильтрации возможно развитие острой почечной недостаточности.
 Дефицит глюкозо 6 фосфатдегидрогеназы • Лабораторная диагностика • Уменьшение количества эритроцитов и Гб, ретикулоцитоз, • тельца Гейнца в эритроцитах, представляющих собой денатурированный гемоглобин. • Осмотическая резистентность эритроцитов нормальная или повышена. • Лейкоцитоз со сдвигом влево до миелоцитов и более молодых форм.
Дефицит глюкозо 6 фосфатдегидрогеназы • Лабораторная диагностика • Уменьшение количества эритроцитов и Гб, ретикулоцитоз, • тельца Гейнца в эритроцитах, представляющих собой денатурированный гемоглобин. • Осмотическая резистентность эритроцитов нормальная или повышена. • Лейкоцитоз со сдвигом влево до миелоцитов и более молодых форм.
 Дефицит глюкозо 6 фосфатдегидрогеназы
Дефицит глюкозо 6 фосфатдегидрогеназы
 Наследственные гемолитические анемии. Гемоглобинопатии. • Наследственные анемии при которых происходит нарушение синтеза глобина. Нарушения синтеза могут быть качественные, обусловленные изменением первичной структуры Гб (серповидноклеточная анемия), и количественные, обусловленные нарушением скорости синтеза одной из цепи глобина (талассемия). • Большинство гемоглобинопатий наследуются аутосомно доминантно. • Встречаются, главным образом в странах жаркого климата.
Наследственные гемолитические анемии. Гемоглобинопатии. • Наследственные анемии при которых происходит нарушение синтеза глобина. Нарушения синтеза могут быть качественные, обусловленные изменением первичной структуры Гб (серповидноклеточная анемия), и количественные, обусловленные нарушением скорости синтеза одной из цепи глобина (талассемия). • Большинство гемоглобинопатий наследуются аутосомно доминантно. • Встречаются, главным образом в странах жаркого климата.
 Серповидноклеточная анемия • вместо гемоглобина А синтезируется гемоглобин S. Отличается он тем, что глютаминовая кислота в нем замещена валином в шестом положении цепи. • Эта замена резко снижает растворимость гемоглобина в условиях гипоксии. Растворимость Гб. S при отдаче кислорода резко уменьшается. Восстановленный гемоглобин S в 100 раз менее растворимый, чем окисленный, и в 50 раз менее растворимый чем гемоглобин А. • В кислой среде он выпадает в осадок в виде кристаллов и деформирует эритроциты, придавая им серповидную форму. Мембрана их теряет прочность, и наступает внутрисосудистый гемолиз.
Серповидноклеточная анемия • вместо гемоглобина А синтезируется гемоглобин S. Отличается он тем, что глютаминовая кислота в нем замещена валином в шестом положении цепи. • Эта замена резко снижает растворимость гемоглобина в условиях гипоксии. Растворимость Гб. S при отдаче кислорода резко уменьшается. Восстановленный гемоглобин S в 100 раз менее растворимый, чем окисленный, и в 50 раз менее растворимый чем гемоглобин А. • В кислой среде он выпадает в осадок в виде кристаллов и деформирует эритроциты, придавая им серповидную форму. Мембрана их теряет прочность, и наступает внутрисосудистый гемолиз.
 • Серповидноклеточная анемия Гемолитические кризы возникают, когда серповидные эритроциты взаимодействуют с тромбоцитами, эндотелием сосудов, так как продвижению по сосудам мешает их форма. Вязкость крови повышается, наступает стаз и микротомбоз сосудов с развитием инфарктов различных органов и тканей. • Клиника. Анемический синдром, тромботические нарушения органов, гепатомегалия, поражение костно сутавной системы (остеомиелит, башенный череп, искревление позвоночника, изменение зубов), неврологические нарушения (обмороки, судороги), отставание в физическом развитии. • Лабораторная диагностика. Анемия нормохромная, анизоцитоз, пойкилоцитоз, базофильная пунктация эритроцитов, серповидноклеточные эритроциты, ретикулоцитоз. Во время гемолитического криза – нейтрофильный лейкоцитоз со сдвигом влево, тромбоцитоз.
• Серповидноклеточная анемия Гемолитические кризы возникают, когда серповидные эритроциты взаимодействуют с тромбоцитами, эндотелием сосудов, так как продвижению по сосудам мешает их форма. Вязкость крови повышается, наступает стаз и микротомбоз сосудов с развитием инфарктов различных органов и тканей. • Клиника. Анемический синдром, тромботические нарушения органов, гепатомегалия, поражение костно сутавной системы (остеомиелит, башенный череп, искревление позвоночника, изменение зубов), неврологические нарушения (обмороки, судороги), отставание в физическом развитии. • Лабораторная диагностика. Анемия нормохромная, анизоцитоз, пойкилоцитоз, базофильная пунктация эритроцитов, серповидноклеточные эритроциты, ретикулоцитоз. Во время гемолитического криза – нейтрофильный лейкоцитоз со сдвигом влево, тромбоцитоз.
 Серповидноклеточная анемия кровь
Серповидноклеточная анемия кровь
норма Серповидно клеточная анемия серповидные эритроциты, анизоциты
норма Серповидно клеточная анемия серповидные эритроциты, анизоциты
 Наследственные гемолитические анемии. Гемоглобинопатии. Талассемия. • Группа наследственных анемий, при которых наличие мутации в гене приводит к торможению синтеза цепей глобина. • Различают и талассемию. • Альфа талассемия Связана с мутациями в генах HBA 1 и HBA 2. Есть всего 4 локуса, кодирующего α цепи. Наличие мутации в одном из локусов приводит к минимальным клиническим проявлениям. Нарушения в двух локусах выражаются лёгкой формой анемии. При мутациях в трёх локусах возникает значительное уменьшение продукции α глобина. Присутствие мутаций во всех четырёх аллелях альфа глобина не совместимо с жизнью. • Бета талассемия — Связана с мутациями в генах цепи. У гетерозигот развивается так называемая малая талассемия, у гомозигот – большая талассемия Кулли с высшей степенью гемолиза эритроцитов. • Клинические проявления талассемий зависят от дисбаланса синтеза цепей Гб. В условиях недостатка синтеза одной цепи, происходит избыточное накопление других цепей, которые агрегируют и откладываются в эритроцитах, подвергающихся усиленному разрушению в селезенке.
Наследственные гемолитические анемии. Гемоглобинопатии. Талассемия. • Группа наследственных анемий, при которых наличие мутации в гене приводит к торможению синтеза цепей глобина. • Различают и талассемию. • Альфа талассемия Связана с мутациями в генах HBA 1 и HBA 2. Есть всего 4 локуса, кодирующего α цепи. Наличие мутации в одном из локусов приводит к минимальным клиническим проявлениям. Нарушения в двух локусах выражаются лёгкой формой анемии. При мутациях в трёх локусах возникает значительное уменьшение продукции α глобина. Присутствие мутаций во всех четырёх аллелях альфа глобина не совместимо с жизнью. • Бета талассемия — Связана с мутациями в генах цепи. У гетерозигот развивается так называемая малая талассемия, у гомозигот – большая талассемия Кулли с высшей степенью гемолиза эритроцитов. • Клинические проявления талассемий зависят от дисбаланса синтеза цепей Гб. В условиях недостатка синтеза одной цепи, происходит избыточное накопление других цепей, которые агрегируют и откладываются в эритроцитах, подвергающихся усиленному разрушению в селезенке.
 Талассемия. • Клиника. Клиническая картина гемолитической анемии с внутриклеточным гемолизом различной степени тяжести, начиная от субклинических форм и кончая тяжелым гемолизом. Развивается желтуха с увеличением содержания непрямого билирубина. Увеличивается селезенка, часто печень. Гомозиготная форма талассемии протекает тяжело с нарушениями роста скелета. Гетерозиготная – более легко, даже бессимптомно. • Диагностика. Гипохромная анемия. Анизоцитоз, пойкилоцитоз, мишеневидные эритроциты. Степень анемии зависит от тяжести гемолиза: Hb 30 40 и выше 100 г/л. Ретикулоциты значительно повышены. Осмотическая резистентность эритроцитов повышена, что является скрининговым тестом на талассемию. • Терапия. При гомозиготной форме основной метод лечения – трансфузии взвеси эритроцитов. У части больных положительный эффект дает спленэктомия. Препараты железа при талассемиях категорически противопоказаны.
Талассемия. • Клиника. Клиническая картина гемолитической анемии с внутриклеточным гемолизом различной степени тяжести, начиная от субклинических форм и кончая тяжелым гемолизом. Развивается желтуха с увеличением содержания непрямого билирубина. Увеличивается селезенка, часто печень. Гомозиготная форма талассемии протекает тяжело с нарушениями роста скелета. Гетерозиготная – более легко, даже бессимптомно. • Диагностика. Гипохромная анемия. Анизоцитоз, пойкилоцитоз, мишеневидные эритроциты. Степень анемии зависит от тяжести гемолиза: Hb 30 40 и выше 100 г/л. Ретикулоциты значительно повышены. Осмотическая резистентность эритроцитов повышена, что является скрининговым тестом на талассемию. • Терапия. При гомозиготной форме основной метод лечения – трансфузии взвеси эритроцитов. У части больных положительный эффект дает спленэктомия. Препараты железа при талассемиях категорически противопоказаны.
 талассемия. Большая талассемия Кулли
талассемия. Большая талассемия Кулли
талассемия мишеневидные эритроциты, гипохромия норма
талассемия мишеневидные эритроциты, гипохромия норма
 Приобретенные гемолитические анемии • Токсичные (гемолитические яды, пчелиный, змеиный яд, стрепто и стафилолизины, нитробензол, фосфор, соли свинца ) • Иммунные • А) изоиммунные в организм извне проникают антитела против эритроцитов или же сами эритроциты, против которых у больного есть собственные антитела (гемолитическая анемия плода и новорожденного, переливание несовместимой крови) • В) гетероиммунные связаны с появлением на поверхности эритроцита • нового антигена (в результате фиксации на эритроцитах медикаментозных препаратов – пенициллина или вирусов), который представляет собой комплекс “ медикамент эритроцит” и “вирус эритроцит” У некоторых лиц на комплексные антигены образуются антитела, в результате чего эритроциты погибают. Лизис их происходит в кровяном русле или они поглощаются макрофагами. • С) аутоиммунные антитела образуются против собственных неизмененных эритроцитов. Гемолизом осложняются такие болезни, как хронический лимфолейкоз, лимфосаркома, миеломная болезнь, системная красная волчанка, ревматоидный полиартрит, злокачественные опухоли. • Механические (протезирование клапанов сердца, маршевая гемоглобинурия после длительной ходьбы или бега по твердой поверхности эритроциты разрушаются в капиллярах стоп )
Приобретенные гемолитические анемии • Токсичные (гемолитические яды, пчелиный, змеиный яд, стрепто и стафилолизины, нитробензол, фосфор, соли свинца ) • Иммунные • А) изоиммунные в организм извне проникают антитела против эритроцитов или же сами эритроциты, против которых у больного есть собственные антитела (гемолитическая анемия плода и новорожденного, переливание несовместимой крови) • В) гетероиммунные связаны с появлением на поверхности эритроцита • нового антигена (в результате фиксации на эритроцитах медикаментозных препаратов – пенициллина или вирусов), который представляет собой комплекс “ медикамент эритроцит” и “вирус эритроцит” У некоторых лиц на комплексные антигены образуются антитела, в результате чего эритроциты погибают. Лизис их происходит в кровяном русле или они поглощаются макрофагами. • С) аутоиммунные антитела образуются против собственных неизмененных эритроцитов. Гемолизом осложняются такие болезни, как хронический лимфолейкоз, лимфосаркома, миеломная болезнь, системная красная волчанка, ревматоидный полиартрит, злокачественные опухоли. • Механические (протезирование клапанов сердца, маршевая гемоглобинурия после длительной ходьбы или бега по твердой поверхности эритроциты разрушаются в капиллярах стоп )
 Приобретенные гемолитические анемии • • • Лабораторная диагностика. Нормохромная или умеренно гиперхромная Ретикулоцитоз Эритронормобластов Нередко наблюдается микросфероцитоз эритроцитов. Осмотическая резистентность эритроцитов в большинстве случаев снижена. В случае острого гемолитического криза встречается лейкоцитоз со сдвигом влево до миелоцитов. Число тромбоцитов не изменено. СОЭ сильно увеличена. В костном мозге наблюдается резко выраженная гиперплазия эритроидного ростка.
Приобретенные гемолитические анемии • • • Лабораторная диагностика. Нормохромная или умеренно гиперхромная Ретикулоцитоз Эритронормобластов Нередко наблюдается микросфероцитоз эритроцитов. Осмотическая резистентность эритроцитов в большинстве случаев снижена. В случае острого гемолитического криза встречается лейкоцитоз со сдвигом влево до миелоцитов. Число тромбоцитов не изменено. СОЭ сильно увеличена. В костном мозге наблюдается резко выраженная гиперплазия эритроидного ростка.
 Гемолитическая болезнь новорожденных • Этиология. Изоимунный конфликт в результате антигенных различий эритроцитов матери и плода (95% на антигены резус, 5% на другие). • Патогенез. Образование изоантител в организме матери наступает во время предыдущих беременностей при попадании эритроцитов плода с антигенами, унаследованными от отца. Чаще всего у резус отрицательных матерей образуются антитела к при резус положительном плоде. Гемолитическая болезнь возникает в результате проникновения антител матери сквозь плаценту в организм плода, где они вызывают внутриклеточный гемолиз эритроцитов. • Клиника. По тяжести зависит от количества антител, поступивших в организм плода. В особо тяжелых случаях может наступить смерть. В менее тяжелых случаях ребенок рождается с явлениями отечности, анемией различной степени тяжести, сердечной недостаточностью, увеличением сердца, печени, селезенки. Желтуха развивается в 1 сутки. Тяжелым осложнением является ядерная желтуха, возникающая в результате интоксикации нервной системы при высоком уровне непрямого билирубина. • Диагностика. Нормохромная анемия, ретикулоцитоз, лейкоцитоз. Уровень непрямого билирубина увеличен пропорционально тяжести гемолиза. • Терапия. Лечение основано на применении обменных переливаний крови
Гемолитическая болезнь новорожденных • Этиология. Изоимунный конфликт в результате антигенных различий эритроцитов матери и плода (95% на антигены резус, 5% на другие). • Патогенез. Образование изоантител в организме матери наступает во время предыдущих беременностей при попадании эритроцитов плода с антигенами, унаследованными от отца. Чаще всего у резус отрицательных матерей образуются антитела к при резус положительном плоде. Гемолитическая болезнь возникает в результате проникновения антител матери сквозь плаценту в организм плода, где они вызывают внутриклеточный гемолиз эритроцитов. • Клиника. По тяжести зависит от количества антител, поступивших в организм плода. В особо тяжелых случаях может наступить смерть. В менее тяжелых случаях ребенок рождается с явлениями отечности, анемией различной степени тяжести, сердечной недостаточностью, увеличением сердца, печени, селезенки. Желтуха развивается в 1 сутки. Тяжелым осложнением является ядерная желтуха, возникающая в результате интоксикации нервной системы при высоком уровне непрямого билирубина. • Диагностика. Нормохромная анемия, ретикулоцитоз, лейкоцитоз. Уровень непрямого билирубина увеличен пропорционально тяжести гемолиза. • Терапия. Лечение основано на применении обменных переливаний крови
 Статистика. Гемолитическая болезнь новорожденных • Частота ГБН составляет от 3 – 6 %. Летальность от данного заболевания на сегодняшний день составляет 2, 5%. • Вероятность развития конфликта по Rh системе составляет до 85%. Однако, несмотря на то, что резус несовместимость матери и плода встречается в 9, 5 13%, ГБН развивается у одного ребенка из 20 25 резус отрицательных женщин. • Вероятность развития конфликта при групповой несовместимости составляет 10%. Наиболее часто конфликт возникает при группе крови матери О(I) и группе крови плода и новорожденного А(II) или В(III). Данный конфликт протекает более легко, чем при Rh несовместимости.
Статистика. Гемолитическая болезнь новорожденных • Частота ГБН составляет от 3 – 6 %. Летальность от данного заболевания на сегодняшний день составляет 2, 5%. • Вероятность развития конфликта по Rh системе составляет до 85%. Однако, несмотря на то, что резус несовместимость матери и плода встречается в 9, 5 13%, ГБН развивается у одного ребенка из 20 25 резус отрицательных женщин. • Вероятность развития конфликта при групповой несовместимости составляет 10%. Наиболее часто конфликт возникает при группе крови матери О(I) и группе крови плода и новорожденного А(II) или В(III). Данный конфликт протекает более легко, чем при Rh несовместимости.
 Гемолитическая болезнь новорожденных, вызванная несовместимостью по антигенам системы AB 0 (групп крови) • По аналогичному механизму возникает анемия у детей, матери которых имеют кровь группы 0. В 10 % беременных имеются антитела против эритроцитарных антигенов А и В, которые принадлежат к классу Іg. G. Они легко проникают через плаценту и разрушают эритроциты плода. Частота этой формы анемии одинакова у детей, рожденных от первой, второй или третьей беременности. • Течение гемолитической болезни при несовместимости матери и плода по антигенам групп крови легче, чем при несовместимости по резус фактору. • Изоиммунизация возможна, если у матери группа крови A, а у плода В и наоборот, но практически гемолитическая болезнь обычно встречается у новорожденных от матерей группы 0, имеющих группу A или В. • Несовместимость по антигенам группы крови имеет место в 20 25% беременностей, но гемолитическая болезнь развивается только у 10% родившихся от них детей. Низкая частота тяжелой гемолитической болезни связана с низкой иммуногенностью антигенов группы крови.
Гемолитическая болезнь новорожденных, вызванная несовместимостью по антигенам системы AB 0 (групп крови) • По аналогичному механизму возникает анемия у детей, матери которых имеют кровь группы 0. В 10 % беременных имеются антитела против эритроцитарных антигенов А и В, которые принадлежат к классу Іg. G. Они легко проникают через плаценту и разрушают эритроциты плода. Частота этой формы анемии одинакова у детей, рожденных от первой, второй или третьей беременности. • Течение гемолитической болезни при несовместимости матери и плода по антигенам групп крови легче, чем при несовместимости по резус фактору. • Изоиммунизация возможна, если у матери группа крови A, а у плода В и наоборот, но практически гемолитическая болезнь обычно встречается у новорожденных от матерей группы 0, имеющих группу A или В. • Несовместимость по антигенам группы крови имеет место в 20 25% беременностей, но гемолитическая болезнь развивается только у 10% родившихся от них детей. Низкая частота тяжелой гемолитической болезни связана с низкой иммуногенностью антигенов группы крови.
 Гемолитическая болезнь новорожденных, вызванная несовместимостью по антигенам системы AB 0 (групп крови) • Несовместимость возникает, если мать имеет 0(1) группу крови, а плод А или В. Однако групповая несовместимость не протекает так тяжело, как резус несовместимость. Это объясняется тем, что антитела А и антитела В относятся к иммуноглобулинам класса М и не проникают через плаценту, тогда как анти резус антитела относятся к иммуноглобулинам класса G, имеют маленькую молекулу и легко проникают через плаценту и вызывают повреждение плода. Сочетание групповой и резус несовместимости крови матери и плода улучшает прогноз и исход родов. • Механизм этого защитного действия связан с конкуренцией систем АВО и Rh фактора, которые ослабляют действия друга. • Эритроциты плода по выходе в материнский кровоток сразу же, еще будучи в межворсинчатом пространстве, блокируются α или β антителами матери и иммунологический конфликт предотвращается. Дальнейшей сенсибилизации ни по одной, ни по другой системе не происходит. • Антитела класса G образуются только у 10 % беременных
Гемолитическая болезнь новорожденных, вызванная несовместимостью по антигенам системы AB 0 (групп крови) • Несовместимость возникает, если мать имеет 0(1) группу крови, а плод А или В. Однако групповая несовместимость не протекает так тяжело, как резус несовместимость. Это объясняется тем, что антитела А и антитела В относятся к иммуноглобулинам класса М и не проникают через плаценту, тогда как анти резус антитела относятся к иммуноглобулинам класса G, имеют маленькую молекулу и легко проникают через плаценту и вызывают повреждение плода. Сочетание групповой и резус несовместимости крови матери и плода улучшает прогноз и исход родов. • Механизм этого защитного действия связан с конкуренцией систем АВО и Rh фактора, которые ослабляют действия друга. • Эритроциты плода по выходе в материнский кровоток сразу же, еще будучи в межворсинчатом пространстве, блокируются α или β антителами матери и иммунологический конфликт предотвращается. Дальнейшей сенсибилизации ни по одной, ни по другой системе не происходит. • Антитела класса G образуются только у 10 % беременных
 • Гемограмма № 1 Задача 1 • Эритроциты 4. 5 х10 12 /л • Гемоглобин 140 г/л • Цв. показатель 0. 9 • Лейкоциты: 8, 0 х 10 9 /л • Базофилы 0. 5 % Эозинофилы 3 % Палочко/яд. 1 % Сегменто/яд. 58 % Лимфоциты 30 % Моноциты 7. 5 % Примечание: Состояние больной оценивается в первые часы после острого кровотечения. Больная бледна, испытывает сильное головокружение, пульс 120 уд/мин. , слабого наполнения; дыхание поверхностное (30 в 1 мин. ); АД – 100/50 мм. рт. ст.
• Гемограмма № 1 Задача 1 • Эритроциты 4. 5 х10 12 /л • Гемоглобин 140 г/л • Цв. показатель 0. 9 • Лейкоциты: 8, 0 х 10 9 /л • Базофилы 0. 5 % Эозинофилы 3 % Палочко/яд. 1 % Сегменто/яд. 58 % Лимфоциты 30 % Моноциты 7. 5 % Примечание: Состояние больной оценивается в первые часы после острого кровотечения. Больная бледна, испытывает сильное головокружение, пульс 120 уд/мин. , слабого наполнения; дыхание поверхностное (30 в 1 мин. ); АД – 100/50 мм. рт. ст.
 Ответ 1 • Гемограмма № 1 • Количество эритроцитов соответствует норме (в среднем норма от 3. 7 до 4. 7 х 1012 /л). • Уровень гемоглобина тоже в пределах нормы (120 140 г/л). • Цветовой показатель не изменен (норма 0. 86 1. 05). • Количество лейкоцитов и лейкоцитарная формула в пределах нормы. • Обратимся к примечанию, в котором отражены клинические симптомы коллапса; вероятнее всего, связанного с кровопотерей. • На основании данных гемограммы и, в основном, примечания можно говорить об: Острой постгеморрагической, нормохромной анемии; стадии коллапса.
Ответ 1 • Гемограмма № 1 • Количество эритроцитов соответствует норме (в среднем норма от 3. 7 до 4. 7 х 1012 /л). • Уровень гемоглобина тоже в пределах нормы (120 140 г/л). • Цветовой показатель не изменен (норма 0. 86 1. 05). • Количество лейкоцитов и лейкоцитарная формула в пределах нормы. • Обратимся к примечанию, в котором отражены клинические симптомы коллапса; вероятнее всего, связанного с кровопотерей. • На основании данных гемограммы и, в основном, примечания можно говорить об: Острой постгеморрагической, нормохромной анемии; стадии коллапса.
 Задача 2 • Гемограмма № 2 • Эритроциты 3. 0 х 10 12 /л • Гемоглобин 62 г/л • Цв. показатель 0. 6 • Сывороточ. железо 8 мкмоль/л. • Лейкоциты: 3. 9 х 109 /л Базофилы 1 % Эозинофилы 2 % Палочко/яд. 2 % Сегменто/яд. 56 % Лимфоциты 34 % Моноциты 6 % • Примечание: Эритроциты гипохромны. Анизоцитоз, пойкилоцитоз. Больной в течении длительного времени страдает язвенной болезнью желудка.
Задача 2 • Гемограмма № 2 • Эритроциты 3. 0 х 10 12 /л • Гемоглобин 62 г/л • Цв. показатель 0. 6 • Сывороточ. железо 8 мкмоль/л. • Лейкоциты: 3. 9 х 109 /л Базофилы 1 % Эозинофилы 2 % Палочко/яд. 2 % Сегменто/яд. 56 % Лимфоциты 34 % Моноциты 6 % • Примечание: Эритроциты гипохромны. Анизоцитоз, пойкилоцитоз. Больной в течении длительного времени страдает язвенной болезнью желудка.
 Ответ 2 • Гемограмма № 2 • Количество эритроцитов снижено (норма в среднем от 3. 7 до 4. 7? 1012 /л). • Уровень гемоглобина низок (норма (120 140 г/л). • Уровень сывороточного железа снижен (норма 11 35 мкмоль/л), а нашем случае 8 мкмоль/л • Остальные показатели без особенностей, лейкоцитарная формула не изменена. • Учитывая данные гемограммы и примечания, мы можем утверждать, что у больного хроническая, гипохромная постгеморрагическая анемия (связанная с длительным существованием, возможно, кровоточащего язвенного поражения желудка); снижение уровня сывороточного железа свидетельствует о недостатке железа в организме больного, поскольку хронические постгеморрагические анемии чаще всего железодефицитны. • Окончательный ответ: Хроническая постгеморрагическая, гипохромная, железодефицитная анемия.
Ответ 2 • Гемограмма № 2 • Количество эритроцитов снижено (норма в среднем от 3. 7 до 4. 7? 1012 /л). • Уровень гемоглобина низок (норма (120 140 г/л). • Уровень сывороточного железа снижен (норма 11 35 мкмоль/л), а нашем случае 8 мкмоль/л • Остальные показатели без особенностей, лейкоцитарная формула не изменена. • Учитывая данные гемограммы и примечания, мы можем утверждать, что у больного хроническая, гипохромная постгеморрагическая анемия (связанная с длительным существованием, возможно, кровоточащего язвенного поражения желудка); снижение уровня сывороточного железа свидетельствует о недостатке железа в организме больного, поскольку хронические постгеморрагические анемии чаще всего железодефицитны. • Окончательный ответ: Хроническая постгеморрагическая, гипохромная, железодефицитная анемия.
 • Гемограмма № 4 Задача 3 • Эритроциты 2. 6 х 10 12 /л • Гемоглобин 85 г/л • Цв. показатель 0. 95 • Ретикулоциты 1. 5 % • Лейкоциты: 3. 5 х 109 /л Базофилы 1% Эозинофилы 5 % Палочко/яд. 1 % Сегменто/яд. 40 % Лимфоциты 20 % Моноциты 4 % Ср. диаметр эритроцита 6. 5 мкм. Осмотическая резистентность: минимальная – 0. 48%, максимальная – 0. 32%. Билирубин: Непрямой 73 мкмоль/л. Содержание стеркобилина увеличено. Примечание: В мазке крови обнаружены микросфероциты. Больной М. , 19 лет, жалуется на слабость, головокружение, периодически возникающую желтуху. Болен с детства.
• Гемограмма № 4 Задача 3 • Эритроциты 2. 6 х 10 12 /л • Гемоглобин 85 г/л • Цв. показатель 0. 95 • Ретикулоциты 1. 5 % • Лейкоциты: 3. 5 х 109 /л Базофилы 1% Эозинофилы 5 % Палочко/яд. 1 % Сегменто/яд. 40 % Лимфоциты 20 % Моноциты 4 % Ср. диаметр эритроцита 6. 5 мкм. Осмотическая резистентность: минимальная – 0. 48%, максимальная – 0. 32%. Билирубин: Непрямой 73 мкмоль/л. Содержание стеркобилина увеличено. Примечание: В мазке крови обнаружены микросфероциты. Больной М. , 19 лет, жалуется на слабость, головокружение, периодически возникающую желтуху. Болен с детства.
 • Гемограмма № 4 Ответ 3 • Количество эритроцитов снижено до 2. 6 х 1012 /л. (норма от 3. 7 до 4. 7 х 1012 /л). • Уровень гемоглобина значительно ниже нормы 85 г/л (норма 120 160 г/л). • Цветовой показатель не изменен. • Средний диаметр эритроцита 6. 5 мкм (норма 7. 5 мкм). • Осмотическая резистентность снижена. • Отмечается незначительная лейкопения; лейкоцитарная формула не изменена. • Повышение уровня прямого билирубина и стеркобилина свидетельствует о гемолизе эритроцитов. • В примечании следует обратить внимание на наличие микросфероцитов (маленьких эритроцитов неправильной формы), а также указание на длительность заболевания (болен с детства). • Учитывая наличие сниженного количества эритроцитов и гемоглобина, а также особенности строения эритроцита (малых размеров, сфероцитарной формы со сниженной резистентностью) плюс явные признаки гемолиза (повышение уровня непрямого билирубина и стеркобилина, желтушность, слабость и головокружение) можно с достоверной точностью утверждать наличие у больного врожденной сфероцитарной гемолитической, нормохромной анемии, а точнее болезни Минковского Шоффара.
• Гемограмма № 4 Ответ 3 • Количество эритроцитов снижено до 2. 6 х 1012 /л. (норма от 3. 7 до 4. 7 х 1012 /л). • Уровень гемоглобина значительно ниже нормы 85 г/л (норма 120 160 г/л). • Цветовой показатель не изменен. • Средний диаметр эритроцита 6. 5 мкм (норма 7. 5 мкм). • Осмотическая резистентность снижена. • Отмечается незначительная лейкопения; лейкоцитарная формула не изменена. • Повышение уровня прямого билирубина и стеркобилина свидетельствует о гемолизе эритроцитов. • В примечании следует обратить внимание на наличие микросфероцитов (маленьких эритроцитов неправильной формы), а также указание на длительность заболевания (болен с детства). • Учитывая наличие сниженного количества эритроцитов и гемоглобина, а также особенности строения эритроцита (малых размеров, сфероцитарной формы со сниженной резистентностью) плюс явные признаки гемолиза (повышение уровня непрямого билирубина и стеркобилина, желтушность, слабость и головокружение) можно с достоверной точностью утверждать наличие у больного врожденной сфероцитарной гемолитической, нормохромной анемии, а точнее болезни Минковского Шоффара.
 СПАСИБО ЗА ВНИМАНИЕ !
СПАСИБО ЗА ВНИМАНИЕ !


